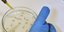

Ένας κάτοικος της Δανίας που ταξίδεψε εκτός της χώρας βρέθηκε θετικός για τον ιό Ζίκα που μεταδίδεται από κουνούπι, μετέδωσε το δίκτυο DR της Δανίας, επικαλούμενο πληροφορίες υγειονομικών αξιωματούχων.
Οι υγειονομικές αρχές της δεύτερης σε μέγεθος πόλης της Δανίας, του Όρχους, δήλωσαν ότι ο ασθενής ταξίδεψε την Νότια και την Κεντρική Αμερική, εστία του ιού.
Ο ιός Ζίκα συνδέεται με εγκεφαλικές βλάβες σε χιλιάδες παιδιά που έχουν γεννηθεί στην Βραζιλία.
Ο ιός χτυπά εγκύους και μωρά και δεν υπάρχει εμβόλιο.
Ακολουθήστε το στο Google News και μάθετε πρώτοι όλες τις ειδήσεις
Δείτε όλες τις τελευταίες Ειδήσεις από την Ελλάδα και τον Κόσμο, στο